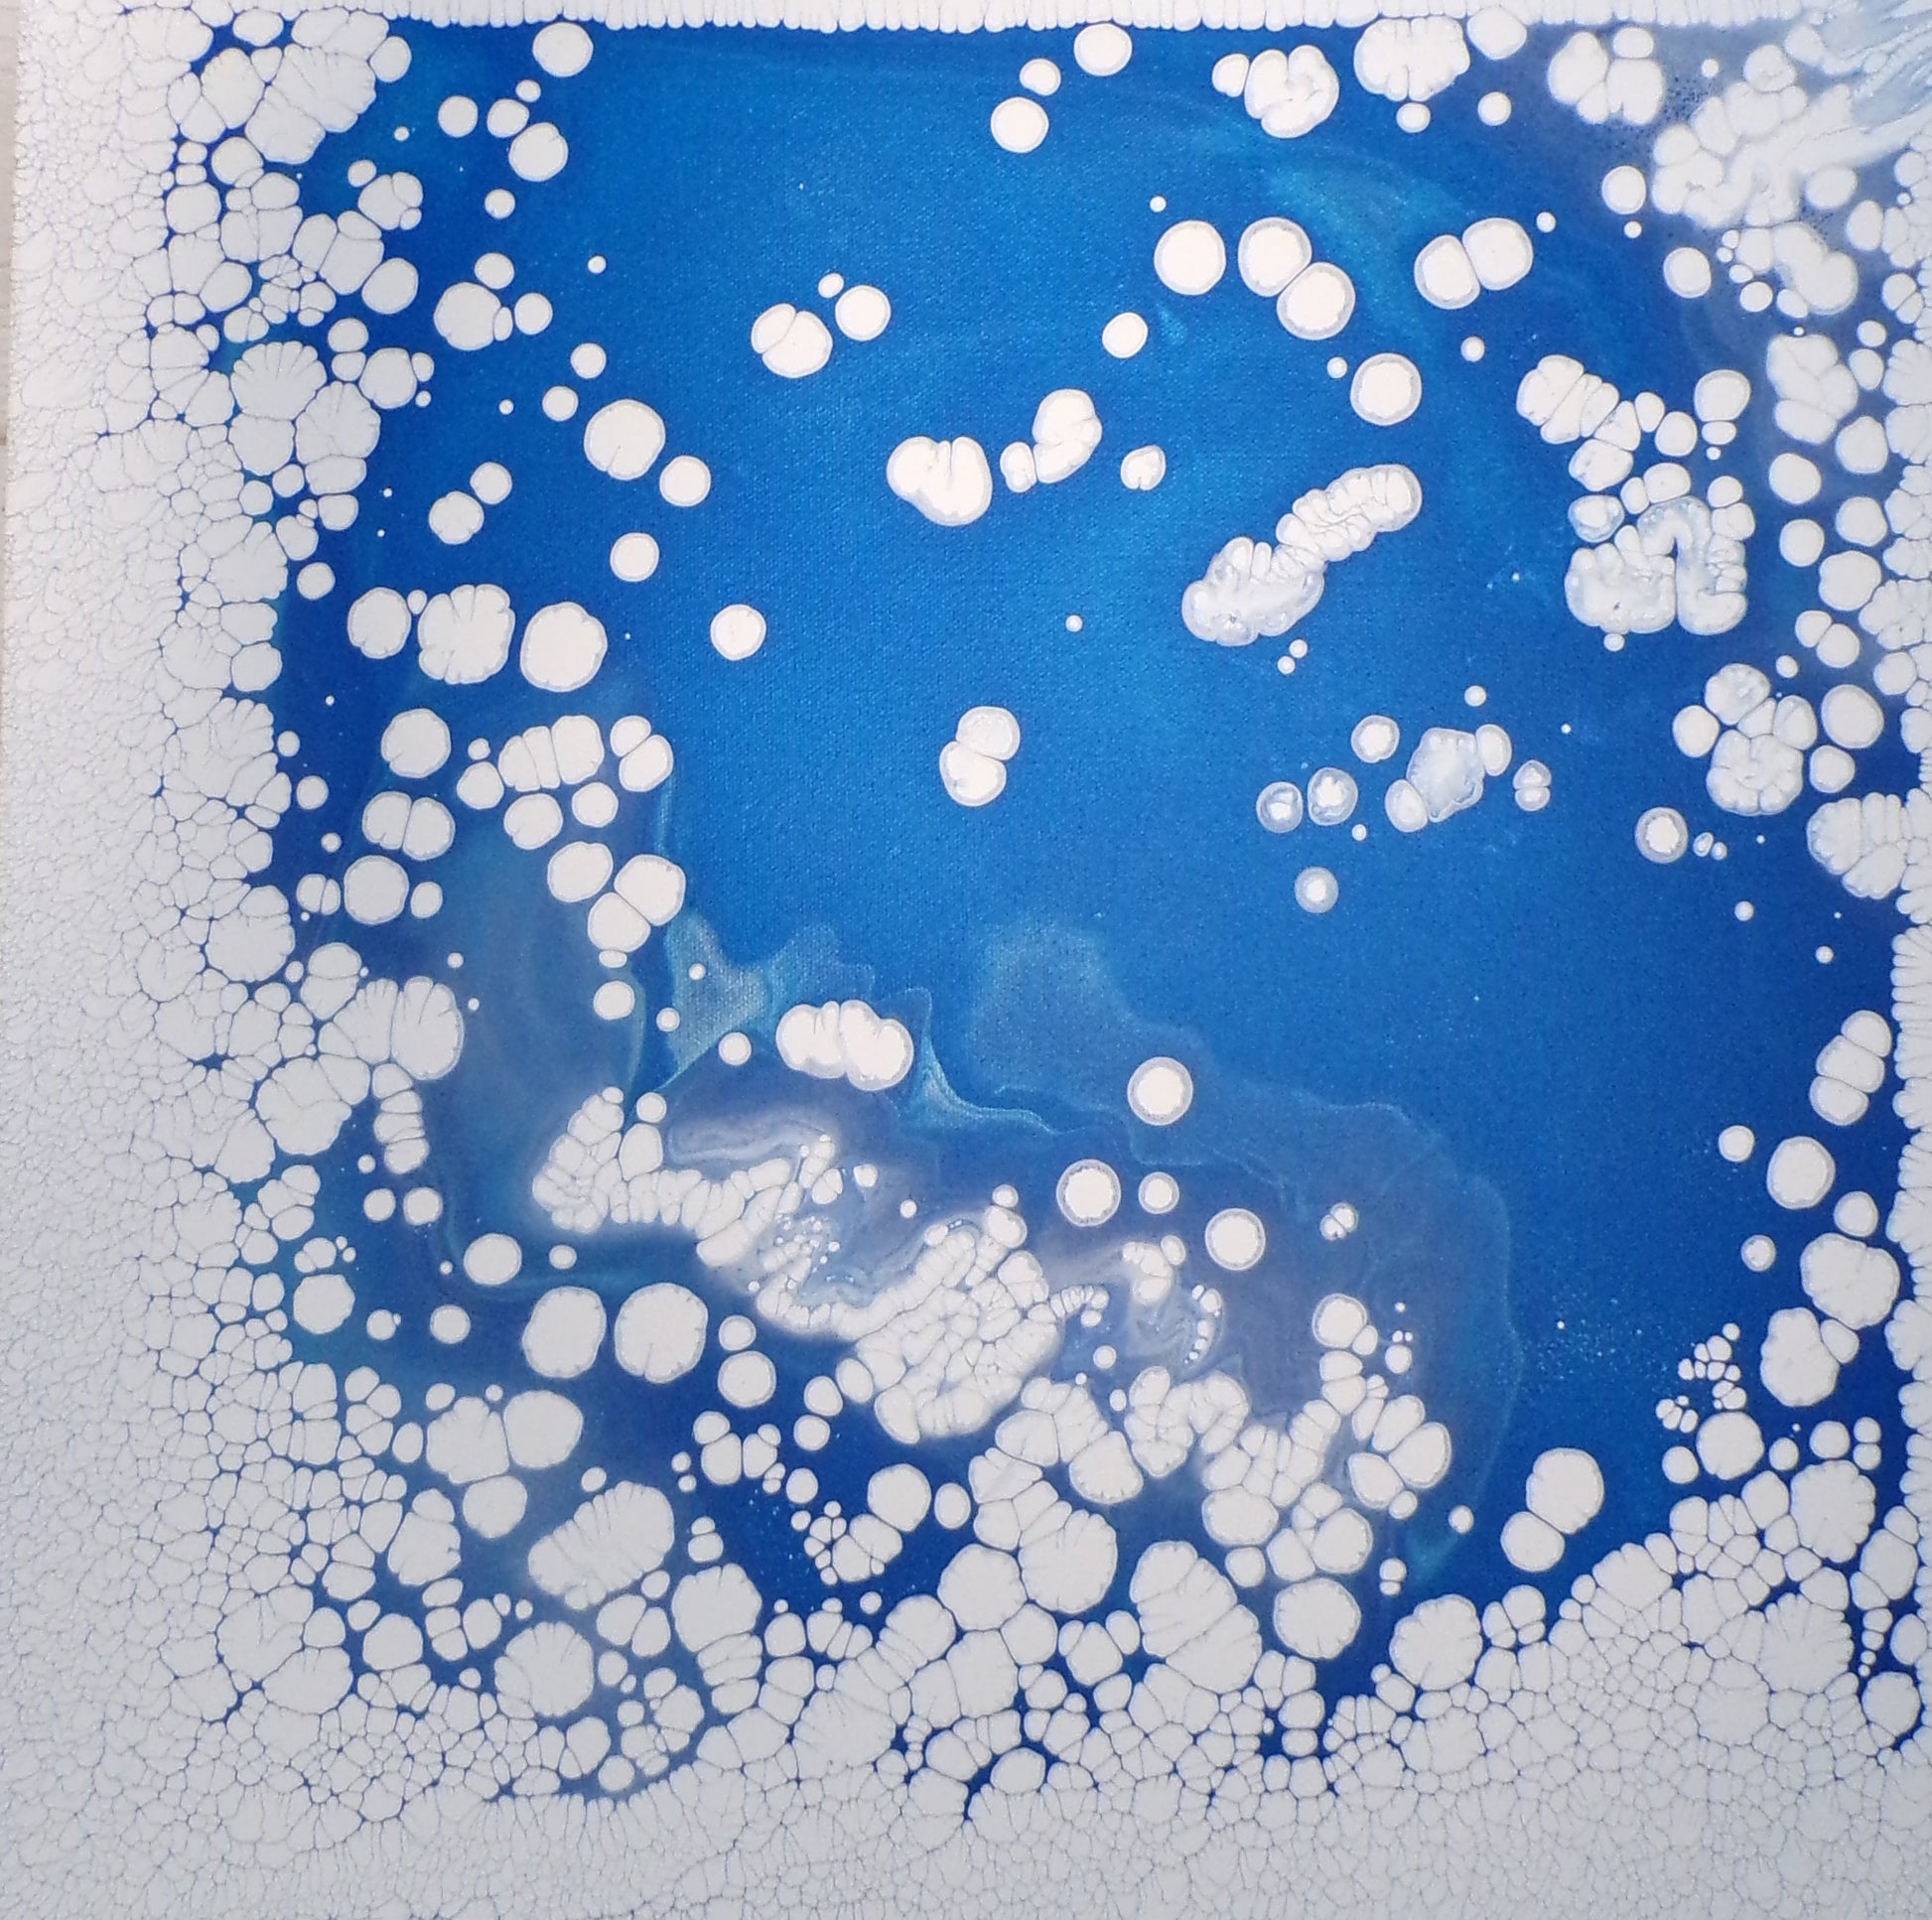

-

"Blue Vase" Print
$25.00"Blue Vase" Print
$25.00 -

"Ocean City Boat" Print
$15.00"Ocean City Boat" Print
$15.00 -

"Peacock Beauty" Print
$40.00"Peacock Beauty" Print
$40.00 -

"Pineapple" Print
$28.00"Pineapple" Print
$28.00 -

"Sylvester" Print
$50.00"Sylvester" Print
$50.00 -

"The Orange" Print
$28.00"The Orange" Print
$28.00 -

"Too Much Dough" Print
$50.00"Too Much Dough" Print
$50.00 -



A Sea of Colors Book
$15.00A Sea of Colors Book
$15.00 -



A to Sea - A Sea Glass Alphabet Book
$15.00A to Sea - A Sea Glass Alphabet Book
$15.00 -








Art Deco Balsam Wood Earrings
$25.00Art Deco Balsam Wood Earrings
$25.00 -



Blue Abyss - Acrylic on Canvas
$375.00Blue Abyss - Acrylic on Canvas
$375.00 -

Blue Crystal Vase - Set of Three
$255.00Blue Crystal Vase - Set of Three
$255.00 -






Blue Crystal Vase Large
$120.00Blue Crystal Vase Large
$120.00 -



Blue Crystal Vase Medium
$90.00Blue Crystal Vase Medium
$90.00 -



Blue Crystal Vase Small
$60.00Blue Crystal Vase Small
$60.00 -


Bottle Lamp
$32.00Bottle Lamp
$32.00 -


Brass Pelican
$36.00Brass Pelican
$36.00 -


Burlap Beach Vibes Bag
$25.00Burlap Beach Vibes Bag
$25.00 -


Butterfly Stud Earrings
$12.00Butterfly Stud Earrings
$12.00 -



Celestial Snow - Acrylic on Canvas
$375.00Celestial Snow - Acrylic on Canvas
$375.00 -





Ceramic Coasters
$10.00Ceramic Coasters
$10.00 -

Ceramic Square Bracelet #663
$12.00Ceramic Square Bracelet #663
$12.00 -




Chadwick & Friends Toddler Book
$12.00Chadwick & Friends Toddler Book
$12.00 -

Chinoiserie Tealight Holders
$6.00Chinoiserie Tealight Holders
$6.00